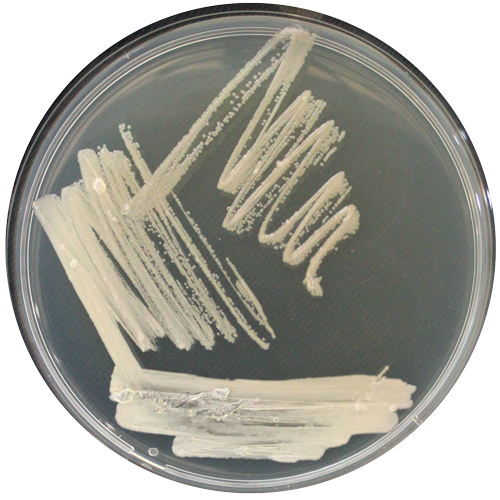

$97.298 más I.V.A.
RGM 3492
Categoría:
Género:
Halomonas
Especie:
titanicae
Cepa tipo:
No
Código de otra colección:
KHS3
Fecha de aislamiento:
2010
País de origen:
Argentina
Historial de deposito:
Instituto de Investigaciones Agropecuarias (INIA) <- Instituto de Investigaciones Biológicas (CONICET, Argentina)
Sustrato de origen:
Agua (agua de mar)
Acceso GenBank:
HM454288
Temperatura óptima de crecimiento:
30º
Regiónalizas secuenciada:
ARNr 16S
Medio de cultivo:
LB suplementado con 20 g/L NaCl
Nivel de riesgo:
Restricciones de distribución:
Consultar https://absch.cbd.int/en/countries/AR. Cepa proveniete de un país con Tratado de Nagoya vigente
Información adicional:
https://doi.org/10.1099/mic.0.001251
Fecha de subida al catálogo:
Secuencias nucleotídicas:
Otros comentarios: